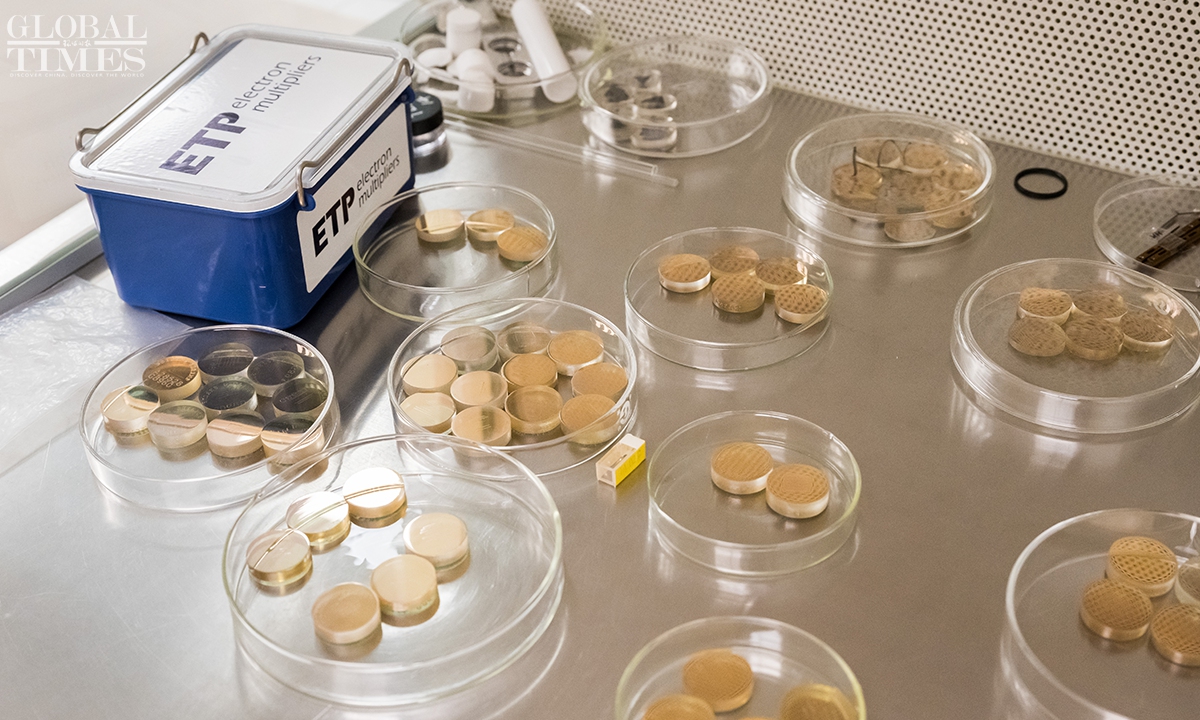

Editor's Note:
Liu Dunyi, a senior research fellow at the Beijing SHRIMP Center, Institute of Geology, Chinese Academy of Geological Sciences, shared with the Global Times in an exclusive interview his experiences of analyzing lunar soil samples three times — once from the US and twice from China. Liu emphasized that China and the US holds complementary strengths in lunar research, and by working together, humanity could significantly accelerate its understanding of the Moon. (Photos: Chen Tao/GT)